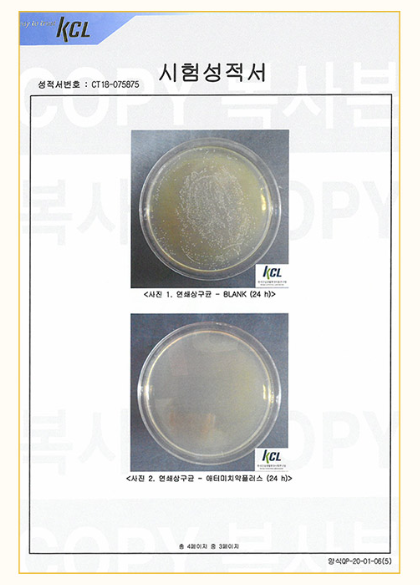

티스토리 뷰
목차
사람들과 이야기할때 입냄새가 나지 않을까.. 입을 가리고 이야기 한적 있으신가요?
매번 충치로 아파하며 치과에 스는 비용이 많아 부담스럽지 않으신가요?
1초에 하나씩 팔리는 치약으로 유명하죠~
애터미 치약 플러스 입니다
이 제품 하나면 아이부터 성인까지 온가족이 그린 프로폴리스로 더 건강하고 상쾌한 구강관리를 할수있습니다.
애터미 치약 효능
▶충치예방효과
▶ 치아미백효과
▶ 구강청결
▶ 음식의 발효 억제
▶ 입냄새 제거
구강건강에 좋은 그린폴리스 사용과 리얼 벌꿀이 첨가된 치약으로
상쾌하고 개운하게 칫솔질 하세요


애터미 치약 가격
타 온라인 상품들은 제조기간, 유통기한 등이 명확하지 않기 때문에
정식 루트를 통해 구매하시어 섭취하시는것이 가장 안전합니다.

애터미 치약 5가지 성분
▶ 충치 예방에 좋은 자이리톨
▶ 입냄새 제거에 좋은 녹차 추출물
▶ 음식발효 억제하는 목약틴크
▶ 치아미백, 구강청결에 좋은 매스틱 오일
▶ 리얼벌꿀이 첨가되어 한경 더 부드러운 세정감


애터미 치약 실험결과
애터미 치약은 실험으로 입증된 건강하고 안전한 기능을 가지고 있습니다.
충치예방 결과

구치측정 결과


반응형

